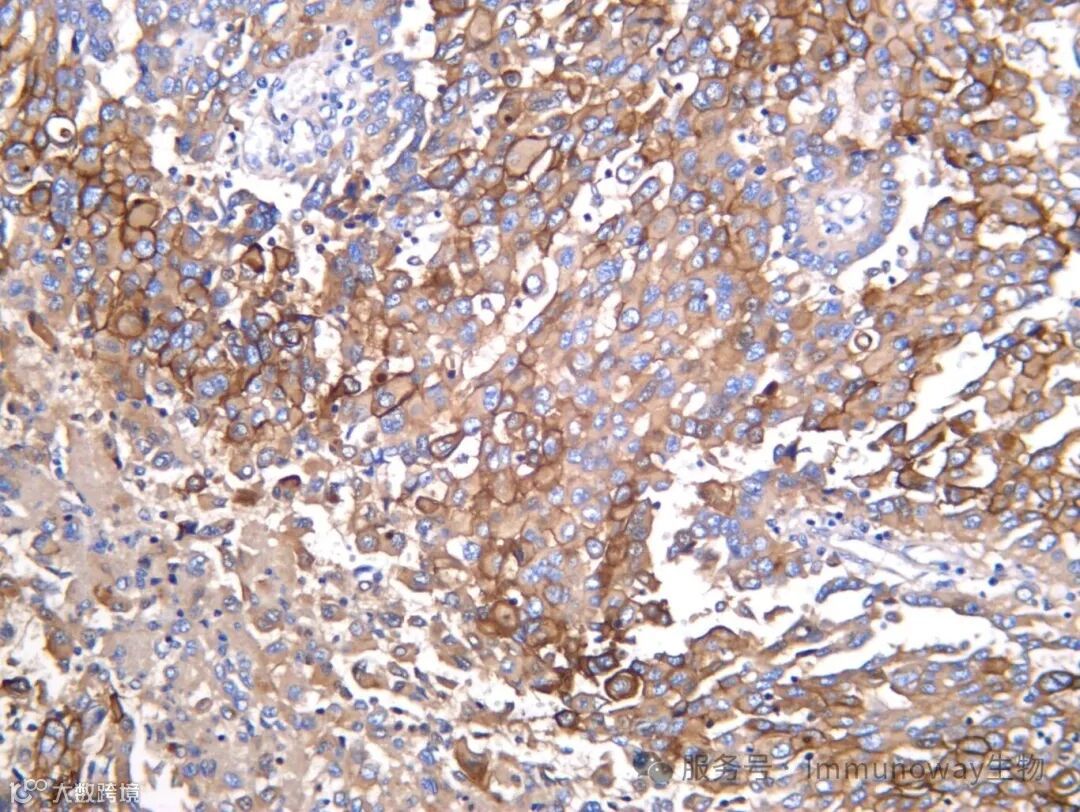

新品上市



ERO1L (PT1488R) PT™ Rabbit mAb
#YM9330
内质网氧化还原稳态的关键调控因子
关键词:内质网应激、氧化还原调控、癌症
ERO1L(内质网氧化还原酶 1 样蛋白)是一种定位于内质网的黄素腺嘌呤二核苷酸(FAD)依赖性氧化酶,在蛋白质折叠过程中通过再生蛋白质二硫键异构酶(PDI)维持氧化还原平衡。ERO1L 在缺氧应激、未折叠蛋白反应(UPR)及肿瘤微环境中发挥重要作用,其异常表达与多种癌症(如肝癌、乳腺癌)的进展和耐药性密切相关。#YM9330 适用于人源样本的Western blot(WB)、免疫组化(IHC)、免疫荧光(IF)和 ELISA 实验。




LIMK-1 (PT1496R) PT™ Rabbit mAb
#YM9338
调控细胞骨架动态的核心激酶。
关键词:细胞骨架、肿瘤转移、信号转导。
LIMK-1(LIM 结构域激酶 1)是 Rho GTP 酶家族下游的关键效应激酶,主要通过磷酸化丝切蛋白(cofilin)抑制其肌动蛋白解聚活性,从而稳定F-actin结构并调控细胞迁移、极性和形态发生。在神经发育中,LIMK-1 参与树突棘形成和突触可塑性;在肿瘤微环境中,其活化常由 ROCK 或 PAK 激酶介导,驱动侵袭性表型。LIMK-1 抑制剂正在被探索用于抑制转移性癌症。#YM9338 适用于人、小鼠和大鼠样本的WB、IHC、IF 和 ELISA 检测。




SHIP-1 (PT1516R) PT™ Rabbit mAb
#YM9358
负调控PI3K信号通路的关键磷酸酶。
关键词:免疫调控、PI3K 通路、癌症。
SHIP-1(SH2 含肌醇 5'-磷酸酶 1)由 INPP5D 基因编码,特异性水解 PIP3 的 5' 磷酸基团生成 PIP2,从而拮抗 PI3K/Akt/mTOR 信号轴,精细调控免疫细胞的活化阈值、增殖与凋亡。在髓系和淋巴系细胞中,SHIP-1 起到“刹车”作用,防止过度炎症反应;其功能缺失或表达下调与自身免疫病、幼年型白血病及实体瘤免疫逃逸密切相关。近年来,SHIP-1 调节剂也被探索用于增强抗肿瘤免疫。#YM9358 适用于人和小鼠样本的WB、IHC、IF、IP 和 ELISA 实验。




Mesothelin (PT1514R) PT™ Rabbit mAb
#YM9356
间皮瘤与卵巢癌的潜在治疗靶点
关键词:癌症、免疫治疗、肿瘤标志物
Mesothelin 是一种 GPI 锚定的细胞表面糖蛋白,在正常成人组织中仅限于间皮细胞低水平表达,但在恶性间皮瘤、胰腺导管腺癌、高级别浆液性卵巢癌(HGSOC)及部分肺腺癌中显著过表达。它通过与 CA125(MUC16)结合介导肿瘤细胞间的粘附,促进腹膜种植转移,并可能激活 NF-κB 和 MAPK 通路以增强生存信号。因其高度肿瘤选择性,Mesothelin 已成为多种免疫疗法(包括 CAR-T 细胞、抗体药物偶联物和双特异性抗体)的核心靶标。#YM9356 适用于人源样本的 WB、IHC、IF、IP 和 ELISA 检测。


新品速递

货号
名称
规格
YM9327
N-RAS (mutated Q61R) (PT1485R) PT™ Rabbit mAb
40μL/100μL/200μL
YM9330
ERO1L (PT1488R) PT™ Rabbit mAb
40μL/100μL/200μL
YM9338
LIMK-1 (PT1496R) PT™ Rabbit mAb
40μL/100μL/200μL
YM9350
TRAP (PT1508R) PT™ Rabbit mAb
40μL/100μL/200μL
YM9356
Mesothelin (PT1514R) PT™ Rabbit mAb40μL/100μL/200μL
YM9358
SHIP-1 (PT1516R) PT™ Rabbit mAb
40μL/100μL/200μL
YM9359
OTX1 (PT1517R) PT™ Rabbit mAb
40μL/100μL/200μL
YM9361
MerTK (PT1519R) PT™ Rabbit mAb
40μL/100μL/200μL
YM9364
AR-β2 (PT1522R) PT™ Rabbit mAb
40μL/100μL/200μL
YM9365
GBA (PT1523R) PT™ Rabbit mAb
40μL/100μL/200μL
YM9366
RARα (PT1524R) PT™ Rabbit mAb
40μL/100μL/200μL
YM9157
ARC (PT1315R) PT™ Rabbit mAb
40μL/100μL/200μL
YM8771
STAT1 (Phospho Ser727) (PT0994R) PT™ Rabbit mAb
40μL/100μL/200μL
YM9326
CD161 (PT1484R) PT™ Rabbit mAb
40μL/100μL/200μL
YM9328
Filaggrin (PT1486R) PT™ Rabbit mAb
40μL/100μL/200μL
YM9321
DC-LAMP (PT1479R) PT™ Rabbit mAb
40μL/100μL/200μL
YM8639
SOX-2 (PT0870R) PT™ Rabbit mAb
40μL/100μL/200μL


新品上市



ERO1L (PT1488R) PT™ Rabbit mAb
#YM9330
关键词:内质网应激、氧化还原调控、癌症
ERO1L(内质网氧化还原酶 1 样蛋白)是一种定位于内质网的黄素腺嘌呤二核苷酸(FAD)依赖性氧化酶,在蛋白质折叠过程中通过再生蛋白质二硫键异构酶(PDI)维持氧化还原平衡。ERO1L 在缺氧应激、未折叠蛋白反应(UPR)及肿瘤微环境中发挥重要作用,其异常表达与多种癌症(如肝癌、乳腺癌)的进展和耐药性密切相关。#YM9330 适用于人源样本的Western blot(WB)、免疫组化(IHC)、免疫荧光(IF)和 ELISA 实验。




LIMK-1 (PT1496R) PT™ Rabbit mAb
#YM9338
调控细胞骨架动态的核心激酶。
关键词:细胞骨架、肿瘤转移、信号转导。
LIMK-1(LIM 结构域激酶 1)是 Rho GTP 酶家族下游的关键效应激酶,主要通过磷酸化丝切蛋白(cofilin)抑制其肌动蛋白解聚活性,从而稳定F-actin结构并调控细胞迁移、极性和形态发生。在神经发育中,LIMK-1 参与树突棘形成和突触可塑性;在肿瘤微环境中,其活化常由 ROCK 或 PAK 激酶介导,驱动侵袭性表型。LIMK-1 抑制剂正在被探索用于抑制转移性癌症。#YM9338 适用于人、小鼠和大鼠样本的WB、IHC、IF 和 ELISA 检测。




SHIP-1 (PT1516R) PT™ Rabbit mAb
#YM9358
负调控PI3K信号通路的关键磷酸酶。关键词:免疫调控、PI3K 通路、癌症。
SHIP-1(SH2 含肌醇 5'-磷酸酶 1)由 INPP5D 基因编码,特异性水解 PIP3 的 5' 磷酸基团生成 PIP2,从而拮抗 PI3K/Akt/mTOR 信号轴,精细调控免疫细胞的活化阈值、增殖与凋亡。在髓系和淋巴系细胞中,SHIP-1 起到“刹车”作用,防止过度炎症反应;其功能缺失或表达下调与自身免疫病、幼年型白血病及实体瘤免疫逃逸密切相关。近年来,SHIP-1 调节剂也被探索用于增强抗肿瘤免疫。#YM9358 适用于人和小鼠样本的WB、IHC、IF、IP 和 ELISA 实验。

Mesothelin (PT1514R) PT™ Rabbit mAb
#YM9356
间皮瘤与卵巢癌的潜在治疗靶点
关键词:癌症、免疫治疗、肿瘤标志物
Mesothelin 是一种 GPI 锚定的细胞表面糖蛋白,在正常成人组织中仅限于间皮细胞低水平表达,但在恶性间皮瘤、胰腺导管腺癌、高级别浆液性卵巢癌(HGSOC)及部分肺腺癌中显著过表达。它通过与 CA125(MUC16)结合介导肿瘤细胞间的粘附,促进腹膜种植转移,并可能激活 NF-κB 和 MAPK 通路以增强生存信号。因其高度肿瘤选择性,Mesothelin 已成为多种免疫疗法(包括 CAR-T 细胞、抗体药物偶联物和双特异性抗体)的核心靶标。#YM9356 适用于人源样本的 WB、IHC、IF、IP 和 ELISA 检测。


新品速递

| 货号 | 名称 | 规格 |
| YM9327 | N-RAS (mutated Q61R) (PT1485R) PT™ Rabbit mAb | 40μL/100μL/200μL |
| YM9330 | ERO1L (PT1488R) PT™ Rabbit mAb |
40μL/100μL/200μL |
| YM9338 | LIMK-1 (PT1496R) PT™ Rabbit mAb | 40μL/100μL/200μL |
| YM9350 | TRAP (PT1508R) PT™ Rabbit mAb | 40μL/100μL/200μL |
| YM9356 | Mesothelin (PT1514R) PT™ Rabbit mAb |
40μL/100μL/200μL |
| YM9358 | SHIP-1 (PT1516R) PT™ Rabbit mAb | 40μL/100μL/200μL |
| YM9359 | OTX1 (PT1517R) PT™ Rabbit mAb | 40μL/100μL/200μL |
| YM9361 | MerTK (PT1519R) PT™ Rabbit mAb | 40μL/100μL/200μL |
| YM9364 | AR-β2 (PT1522R) PT™ Rabbit mAb | 40μL/100μL/200μL |
| YM9365 | GBA (PT1523R) PT™ Rabbit mAb | 40μL/100μL/200μL |
| YM9366 | RARα (PT1524R) PT™ Rabbit mAb | 40μL/100μL/200μL |
| YM9157 | ARC (PT1315R) PT™ Rabbit mAb | 40μL/100μL/200μL |
| YM8771 | STAT1 (Phospho Ser727) (PT0994R) PT™ Rabbit mAb | 40μL/100μL/200μL |
| YM9326 | CD161 (PT1484R) PT™ Rabbit mAb | 40μL/100μL/200μL |
| YM9328 | Filaggrin (PT1486R) PT™ Rabbit mAb | 40μL/100μL/200μL |
| YM9321 | DC-LAMP (PT1479R) PT™ Rabbit mAb | 40μL/100μL/200μL |
| YM8639 | SOX-2 (PT0870R) PT™ Rabbit mAb | 40μL/100μL/200μL |




